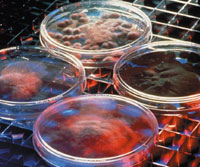
В одном миллилитре жидкости может содержаться до миллиарда бактерий, а потенциальная емкость памяти на базе бактерий поистине колоссальна

Computerworld, США
Системы хранения, в которых носителями данных являются… бактерии, способны нести в себе информацию на протяжении тысячелетий, защищая ее даже от ядерных взрывов, умещая 250 Тбит данных на одном квадратном дюйме поверхности. Органические тонкопленочные структуры выдерживают более 20 тыс. циклов чтения и записи
Фантастические показатели производительности и емкости систем хранения, основанных на достижениях биотехнологий, находятся за гранью воображения. Исследования показывают, что хранить данные в геноме живого организма не только возможно, но и целесообразно. Получить доступ к ним в этом случае можно спустя сотни или даже тысячи лет после того, как организм воспроизведет свой генетический код в сотнях поколений.
Фантастические показатели производительности и емкости систем хранения, основанных на достижениях биотехнологий, находятся за гранью воображения. Исследования показывают, что хранить данные в геноме живого организма не только возможно, но и целесообразно. Получить доступ к ним в этом случае можно спустя сотни или даже тысячи лет после того, как организм воспроизведет свой генетический код в сотнях поколений.
«В одном миллилитре жидкости может содержаться до миллиарда бактерий, а потенциальная емкость памяти на базе бактерий поистине колоссальна», — подчеркнул ведущий научный сотрудник лаборатории Pacific Northwest National Laboratory Пак Вонг.
Вонг с группой других исследователей описал проводившийся тремя годами ранее эксперимент, в ходе которого ученым удалось сохранить в одной бактерии цифровую информацию в форме комплементарных пар оснований нуклеиновых кислот; около 100 пар оказалось достаточно для того, чтобы закодировать одну среднюю английскую фразу.
В начале этого года ученые из Института современных биологических наук при Университете Кейо опубликовали результаты аналогичных исследований. В обычной бактерии сенной палочки им удалось успешно закодировать фразу «e=mc^2 1905!» — основную формулу теории относительности Эйнштейна и год, когда она была выведена. Согласно утверждению ученых, данные, сформированные на основе ДНК, также могут быть использованы для долгосрочного хранения больших информационных файлов.
Одна из задач, стоявших перед группой Вонга, заключалась в поиске «безопасного убежища» молекулам ДНК, которые легко разрушались в любой открытой среде. Так называемый «двухнитевый разрыв ДНК», который обычно является фатальным, может быть вызван общими неблагоприятными условиями окружающей среды, в том числе повышенной температурой, а также избытком или недостатком влаги.
Памятуя о хрупкости ДНК, исследователи создали опытный образец хранилища, позволяющего добавлять искусственные последовательности генов и обеспечивать выживание в экстремальных условиях. Важно, что хранилище со встроенной в него информацией было способно расти и развиваться.
Пожалуй, самый сложный для исследователей вопрос был связан с выборкой сохраненных сообщений.
«Выборка информации, хранящейся в бактерии, остается процессом, который требует определенных затрат времени и сил. В 2000 году на выполнение процедуры извлечения информации у нас уходило два часа, — отметил Вонг. — На то, чтобы довести технологию выборки данных до уровня современных коммерческих ИТ-систем, понадобятся десятилетия».
Большая часть областей применения потенциальных приложений для средств хранения данных на основе ДНК связана с ядерными проектами Министерства энергетики США, которое и финансировало работы Вонга. К числу приложений, связанных с безопасностью, относится маскировка информации и стеганография — сокрытие данных внутри других данных, — предназначенная для коммерческих продуктов, а также для систем обеспечения национальной безопасности.
На уровне атомов
По словам профессора Университета штата Висконсин Франца Химпсела, в 1959 году Ричард Фейнман произнес знаменитую речь There’s Plenty of Room at the Bottom («Внизу места полно»), в которой попытался ответить, возможно ли уменьшать размеры устройств вплоть до уровня атомов. Уже тогда он предсказывал, что вся печатная информация, накопленная за многие столетия с момента издания Библии Гуттенберга, в один прекрасный день сможет уместиться в кубе со стороной в 0,1 мм, едва различимом невооруженным глазом. По словам Фейнмана, в конечном итоге один бит информации будет храниться в одном атоме. Для предотвращения возможных помех отдельные биты будут размещать на расстоянии в несколько атомов друг от друга.
В 2002 году двухмерная версия атомной памяти Фейнмана была воспроизведена с помощью золотого напыления на поверхности кремния, упорядоченного в виде дорожек. Это было похоже на диск CD-ROM, только измерялось все не в микронах, а в нанометрах. Соответственно, и плотность размещения, основанная на возможности хранения одного бита данных в одном атоме, оказывалась в миллион раз выше.
«Минимальное пустое пространство вокруг каждого бита занимает пять атомов в длину и четыре в ширину, между двумя соседними дорожками находится четыре атома, — отметил Химпсел. — Таким образом, высказанное Фейнманом в 1959 году предположение о том, что биты должны отстоять один от другого на пять атомов, получило практическое подтверждение».
В отличие от хранилища на основе бактерий доступ к атомному хранилищу получить гораздо легче. Чтение памяти состоит из простого сканирования линий с помощью туннельного микроскопа, фокус которого перемещается вдоль дорожек. Для того чтобы определить местоположение бита, нет необходимости осуществлять поиск в двух направлениях. Поскольку все атомы имеют одинаковый размер и находятся в ячейках кристаллической решетки, сигнал достаточно предсказуем.
С записью данных все обстоит сложнее и требует больших временных затрат. Хотя плотность хранения составляет 250 Тбит на квадратный дюйм, скорость передачи данных остается крайне низкой. По мере уменьшения размера бита в процессе чтения выделяется все меньше энергии. Для достижения приемлемого уровня сигнал/шум на интеграцию уходит больше времени. Даже теоретический предел скорости передачи данных с использованием самой лучшей электроники оказывается намного ниже, чем у современных жестких дисков. Скорость передачи настолько низка, что на запись квадратного сантиметра данных уйдет около миллиона лет.
Впрочем, все это нисколько не смущает Химпсела, исследования которого финансирует Национальный научный фонд США. «Наша конечная цель заключается в том, чтобы довести плотность хранения данных до того предела, который допускает природа, — говорит он. — Здесь мы заходим настолько далеко, что какое-либо практическое применение полученным результатам найти вряд ли удастся, но мы и не ставим перед собой такой задачи».
Химпсел сравнил память на основе атомов кремния с памятью на базе ДНК. Выяснилось, что для хранения одного бита в ДНК понадобится 32 атома, а на кремниевой поверхности — 20 атомов.

